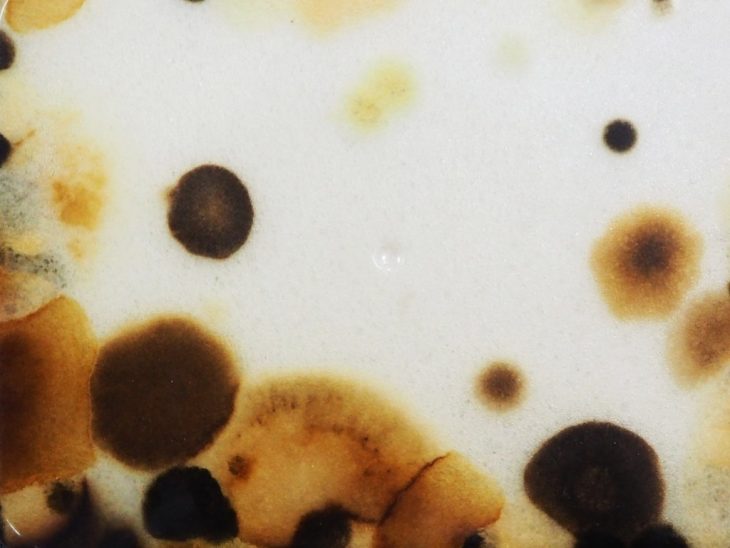

Foaminant-Foam Scaffolds for Mineralised Tissue.
Mixed bio plastic foam composites are used as scaffolds for species to proliferate inside and around the materials by contamination process using our body to contact with the mold before printing in order to create a unique pattern by the growth of fungi following the traces of the human body path on the mold. The material appearance has been changed due to the colonization of species depending on the different environment that human body has been exposed.
The material properties have been explored through the chair design in order to promote the interaction between user and material in the way that the material is contaminated by human body. The design of the geometries are based on uniquely ergonomic design considering human figure by 3d scanning different people using as the inputs for designing each chairs differently as well as the feedback loop between digital and physical analysis with the structure analysis software which is capable of analyze the overall geometry comparing with actual chair in physical world, also the local geometry which is computationally designed and inspired by the nature in order to achieve the structural properties both deformation and utilization of the material, and test with how the actual material behave.
The fabrication processes have been developed through additive manufacturing process controlling by Kuka robotic arm attached with the tools which are designed for 3d printing bio plastic foam on the mold of the chair. The idea of the tools is to make the static extruder which can print continuously using gravity force with the studies of material viscosity to be able to print bio plastic as the first layer in order to manipulate the growth of fungi, and give the domain of the growth by printing the layer of bio plastic foam as a boundary, and moving the mold in 6 axis which can control the flow of the material during it is printed by robotic arm following the G-code path generating from the designs.
Foaminant is a project of IaaC, Institute for Advanced Architecture of Catalonia
developed at Research & Development Studio, e.g. Master in Advanced Architecture 02 in 2016-2017 by:
Students: Inthat Ueasak-aree
Faculty: Marcos Cruz
Assistant: Nina Jotanovic
Biology Support: Nuria Conde Pueyo
Robotic fabrication support: Alexandre Dubor, Kunaljit Singh Chadha, Raimund Krenmueller